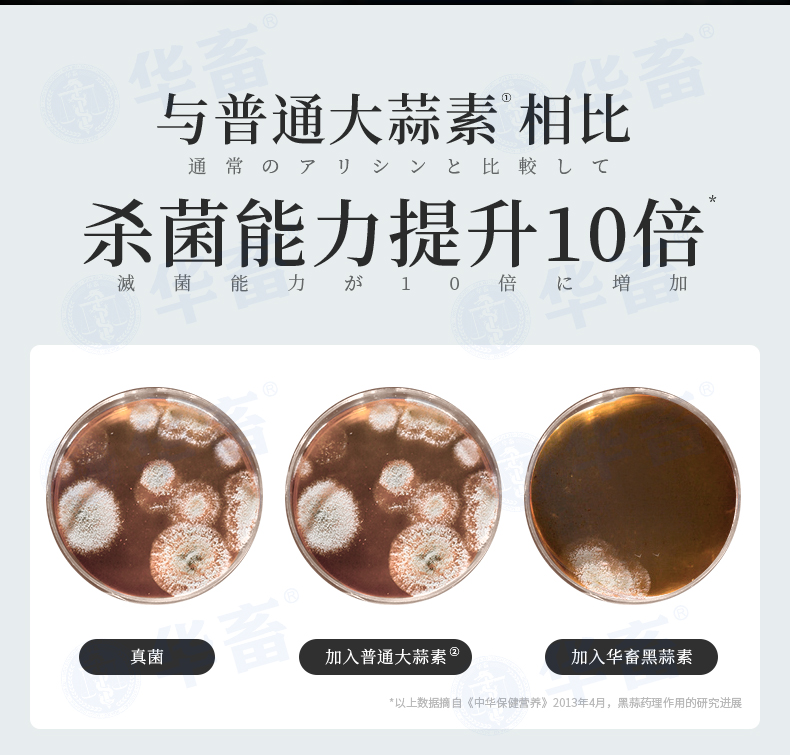

华畜 黑蒜素20斤装 大蒜素升级版 杀菌能力提升10倍 禽畜水产通用饲料添加剂
¥58.90
| 运费: | ¥ 0.00-999.00 |
| 库存: | 99812 件 |
商品详情

- 华畜官方微信旗舰店 (微信公众号认证)
- 扫描二维码,访问我们的微信店铺
- 随时随地的购物、客服咨询、查询订单和物流...